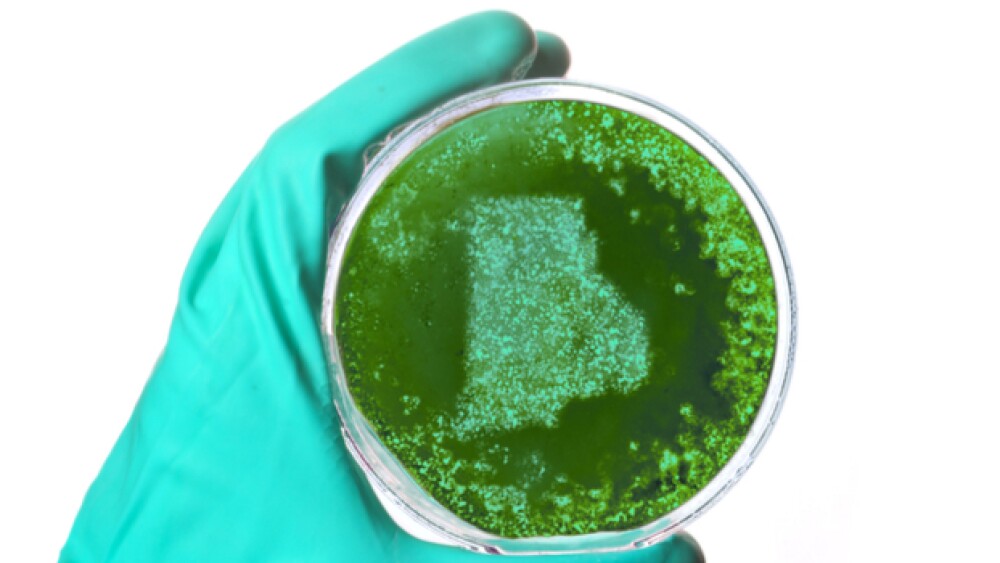

While Boston tends to get the lion’s share of recognition as the premier biopharma hub on the East Coast of the United States, other cities and states are looking to make their names known as a strong location for the industry.
While Boston tends to get the lion’s share of recognition as the premier biopharma hub on the East Coast of the United States, other cities and states are looking to make their names known as a strong location for the industry.
New Jersey, New York and New Hampshire have gone to great lengths to distinguish themselves, but so too has tiny Rhode Island. Carol Malysz, executive director of RI Bio, told BioSpace that Rhode Island that the Ocean State has a number of characteristics that make it an attractive place for biotechs to set up shop. Not only is it in close proximity to Boston and New York, she said the state has a strong educational system that provides employers with a deep talent pool.
The state is home to numerous early-stage life sciences companies, world-class biopharma manufacturing facilities and successful medical device and design innovation companies, she said. Earlier this year several innovation sites were announced for Rhode Island that includes the University of Rhode Island and Arizona State University Innovation Hub, The Rhode Island “iHub” and Rhode Island Agricultural Innovation & Entrepreneurship Campus. These three spots are expected to create hundreds of jobs in rapidly growing advanced industries, including cybersecurity, data analytics and agricultural technology.
“Firms like Amgen, a biopharmaceutical company, and Rubius, which pioneers blood cell therapies, have chosen to open facilities in the state. They join homegrown biotech firms like EpiVax to create a thriving biotech community that generates top-notch products and encourages innovation,” Malysz said.
When Amgen opened up its facility, it said the Rhode Island plant is a “first-of-its-kind in the U.S.” Amgen expects to invest up to $200 million in the approximately 120,000 sq. ft. plant and anticipates creating approximately 150 additional highly-skilled manufacturing positions. Rubius is renovating a former Alexion Pharmaceuticals plant in Smithfield, RI. When all is said, the company plans to invest up to $95 million through 2020, and up to $155 million in total over a five-plus year period, and it expects to hire approximately 150 people to be employed at the Rhode Island facility.
The investments from companies like those have been on the rise in the state and have raised the profile of Rhode Island, Malysz said. The Amgen and Rubius expansions demonstrate the new strengths of Rhode Island, she said. The investments are dispelling some of the concerns regarding lost industry jobs the state has seen in the area over the past decade. Malysz noted that bioscience is one of the top five fastest-growing industry sectors in Rhode Island. She said there is some chance for “spillover” from the Boston area due to the fact that Rhode Island is “well-positioned as a more affordable alternative for life sciences companies.”
While the state continues to be a beneficiary of some life sciences-related infrastructure investments from the National Institutes of Health and others, one area that Malysz and RI Bio are hoping to boost is in the area of venture capital investments. Malysz said there is a need for greater VC funding in the state due largely to the fact that most investors have their eyes fixed on Boston. She said encouraging more capital to be invested in the state is a problem that remains to be solved, but noted that RI Bio and state leaders are working toward that.
“Even though in the last several years, the entire startup ecosystem has improved, to attract capital RI needs more wins. The state needs high visibility companies with demonstrated growth supported by local connections and resources. By strengthening mentorship and advice from experienced investors like the state’s Slater Fund, Cherrystone Angel Group, and Biograph Ventures, RI can continue to foster the growth and investment in growing life sciences enterprises,” Malysz said.
In the meantime, Malysz said that for now, the state has a better chance of turning out enterprises that will be attractive to both in and out-of-state investors by leveraging homegrown connections, resources and capital.
In addition to boosting the state’s life sciences profile, Malysz said Bio RI is working closely with groups like MassBio and BioCT to determine how they can combine their strengths and grow a strong Northeast region.